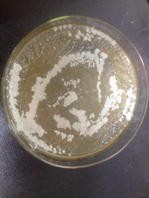

Table 2 Colony morphology of Pb2+ medium
500 mg/L | 1000 mg/L | 1500 mg/L | 2000 mg/L |
|---|---|---|---|
|
|
|
|
Well growth | Slow growth | Slow growth | Slow growth and some variation |